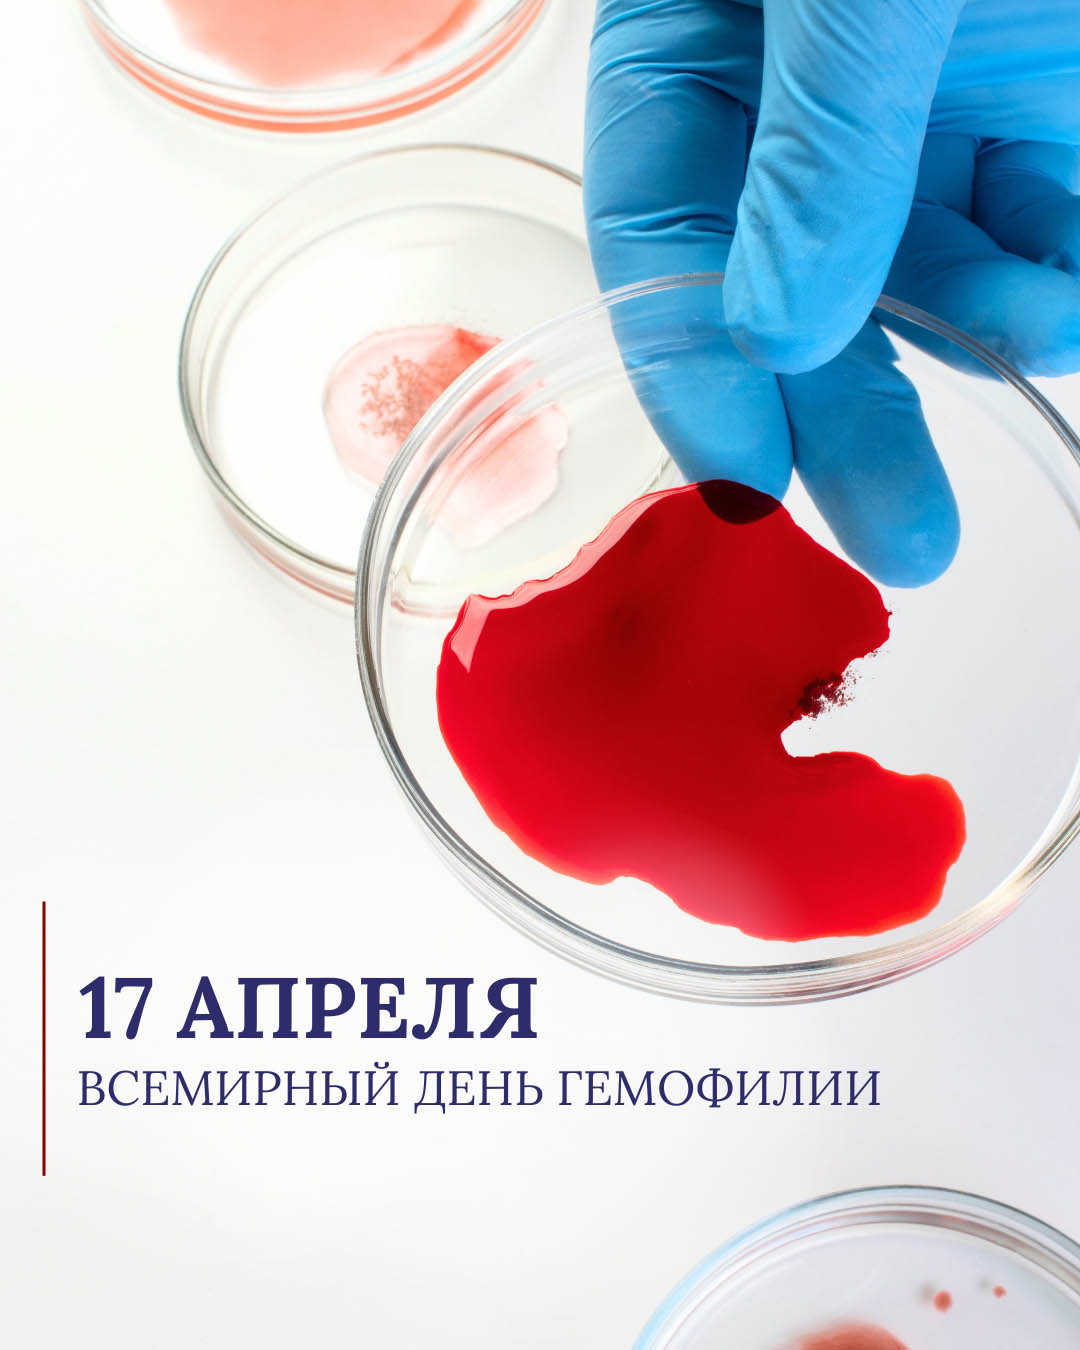

Ежегодно 17 апреля отмечается Всемирный день гемофилии.
Основная цель этого события — привлечь внимание международных организаций, политиков, общественности и сотрудников системы здравоохранения к проблемам больных с гемофилией, повысить осведомленность об этом хоть и не частом, но тяжелом наследственном недуге.
Дата 17 апреля определена в честь дня рождения основателя Всемирной федерации гемофилии (WFH) Франка Шнабеля.
Тема Всемирного дня гемофилии 2026 года — «Диагностика: первый шаг к лечению». По оценкам WFH, более трех четвертей людей с гемофилией (как и с другими нарушениями свертываемости крови) не имеют диагноза.
Гемофилия — наследственное нарушение свертываемости крови, вызванное мутациями генов, расположенных в X-хромосоме. Различают три типа гемофилии (A, B, C). Болезнь связана с полом, поэтому болеют преимущественно мужчины, наследуя ее от матерей-носительниц. По некоторым оценкам, сегодня количество больных гемофилией в мире составляет 400 тыс. человек (один из 10 тыс. мужчин).
Виновницей распространения гемофилии по царствующим династиям Европы считают английскую королеву Викторию, у которой, очевидно, произошла генная мутация. Виктория всю жизнь чувствовала себя отлично, но передала свой патологический ген этой ужасной болезни в царствующие династии ряда европейских стран.
На сегодняшний день гемофилия не поддается излечению, болезнь контролируется с помощью инъекций недостающего фактора свертываемости. Диагноз «гемофилия» больше не является приговором, но до окончательной победы еще далеко.
Рекомендуем новые издания из фонда Республиканской научной медицинской библиотеки по гематологии и, в частности, по проблеме гемофилии:
- Дмитриев, Е. В. Факторы риска и медицинская профилактика ингибиторной формы гемофилии А у детей : автореф. дис. … канд. мед. наук / Дмитриев Евгений Вячеславович ; Республиканский научно-практический центр детской онкологии, гематологии и иммунологии, Республиканский научно-практический центр трансфузиологии и медицинских биотехнологий. – Минск, 2025. – 22 с.
Диссертационное исследование Е.В. Дмитриева посвящено снижению риска образования ингибиторов фактора VIII у детей с тяжелой гемофилией А. Доказана эффективность персонализированной профилактики, включающей анализ генетических рисков (нулевые мутации гена) и использование алгоритма авторской компьютерной программы «Antihemokalculator» для расчета доз.
- Кабаева, Е. Н. Эпидемиология гемофилии и организация медицинской помощи пациентам с гемофилией в Республике Беларусь / Е. Н. Кабаева // Гематология. Трансфузиология. Восточная Европа. – 2022. – Т. 8, № 1. – С. 72–80.
В статье представлены основные статистические данные в зависимости от тяжести и формы гемофилии, наличия ингибиторов, а также распределение по регионам Республики Беларусь.
- Павлова, В. Ю. Приобретенная гемофилия: от симптома к диагнозу / В. Ю. Павлова, А. И. Кретц, Е. А. Туренко // Тромбоз, гемостаз и реология. – 2024. – № 4. – С. 4–11.
В статье освещаются алгоритмы лабораторной диагностики, принципы контроля терапии и клинические проявления, направленные на раннее выявление и купирование кровотечений редкого иммунного заболевания с высокой смертностью.
- Профилактика ингибиторной формы тяжелой гемофилии А у детей в Республике Беларусь: 12-летний опыт работы / Е. В. Дмитриев [и др.] // Вопросы гематологии / онкологии и иммунопатологии в педиатрии. – 2023. – Т. 22, № 3. – С. 36–42.
Цель исследования – определить эффективность профилактики возникновения патологических ингибиторов свертывания у РНЛП (или минимально леченных пациентов) с тяжелой гемофилией А путем введения плазменного концентрата фактора свертывания крови.
- Резолюция совета экспертов «Генная терапия гемофилии В: новая реальность» / Е. Н. Паровичникова [и др.] // Тромбоз, гемостаз и реология. – 2025. – № 3. – С. 87–91.
Резолюция Экспертного совещания утверждает место валоктокогена роксапарвовека как первого генно-терапевтического препарата для лечения тяжелой гемофилии А. Эксперты определили критерии отбора пациентов, необходимость мультидисциплинарного подхода и мониторинга безопасности для внедрения метода в клиническую практику Российской Федерации.
- Резолюция Экспертного совещания по вопросу применения препарата валоктокоген роксапарвовек у пациентов с гемофилией А / Т. А. Андреева, Н. И. Зозуля // Педиатрия. Журнал имени Г. Н. Сперанского. – 2024. –Т. 103, № 1. – С. 196–197.
Исследование посвящено анализу внедрения инновационных методов генной терапии в России. Эксперты отмечают, что метод обеспечивает долгосрочный синтез фактора IX, снижает частоту кровотечений, избавляет от необходимости регулярных инфузий и улучшает качество жизни пациентов.
- Результаты одноцентрового исследования приверженности к терапии эмицизумабом у пациентов с гемофилией А: первое исследование в России / Т. А. Андреева [и др.] // Тромбоз, гемостаз и реология. – 2025. – № 3. – С. 40-46.
Первое в России одноцентровое исследование показало высокую приверженность (adherence) пациентов с гемофилией А к профилактике эмицизумабом. Удобство подкожного введения раз в 1-4 недели обеспечивает долгосрочную эффективность, снижение частоты кровотечений и высокую удовлетворенность лечением, подтверждая результаты международных исследований.
- Система гемостаза. Теоретические основы и клиническая практика. Национальное руководство [ / [С. А. Алексеев и др.] ; под ред.: О. А. Рукавицына, С. В. Игнатьева. – М. : ГЭОТАР-Медиа, 2024. – 942 с.
Первое фундаментальное российское национальное руководство, где подробно описаны современные представления о свертывании крови, диагностике и лечении тромбозов и геморрагий, детально разобраны механизмы первичного (сосудисто-тромбоцитарного) и вторичного (коагуляционного) гемостаза. В книгу включены разделы по ведению нарушений гемостаза в различных областях медицины.
- Скворцов, В. В. Гемофилия в практике врача-терапевта и гематолога / В. В. Скворцов, К. А. Дурноглазова, О. А. Лешина // Справочник врача общей практики. – 2022. – № 11. – С. 7–16.
Статья посвящена диагностике и лечению наследственного дефицита факторов свертывания крови VIII и IX и ориентирована на повышение компетенций врачей в своевременном выявлении и ведении пациентов с данным заболеванием. В работе рассматриваются клинические проявления, алгоритмы диагностики и современные методы заместительной терапии гемофилии А и В для терапевтов и гематологов.
- Стандарт медицинской помощи взрослым при гемофилии А (диагностика, лечение и диспансерное наблюдение) (приказ Минздрава России от 10.07.2024 № 352н). Стандарт медицинской помощи взрослым при гемофилии В (диагностика, лечение и диспансерное наблюдение) (приказ Минздрава России от 10.07.2024 № 352н) // Урология. Стандарты медицинской помощи. Критерии оценки качества. Фармакологический справочник. – 2-е изд. – М. : ГЭОТАР-Медиа, 2025. – С. 88–102.
В статье представлены стандарты лечения, критерии оценки качества и фармакологические рекомендации. Это позволяет оперативно находить утвержденные методики лечения для оценки эффективности оказанной помощи.
- Эволюция лечения гемофилии: от трансфузии донорской крови к таргетной терапии / О. В. Солдатенкова [и др.] // Трансфузиология. – 2022. – Т. 23, № 4. – С. 389–403.
Статья описывает путь развития терапии гемофилии от переливаний цельной крови к использованию концентратов факторов свертывания и современным таргетным препаратам (эмицизумаб). Освещены вопросы повышения эффективности профилактики, снижения риска ингибиторов и улучшения качества жизни пациентов.
Для углубленного изучения темы рекомендуем обратиться к ресурсам Электронной медицинской библиотеки.

